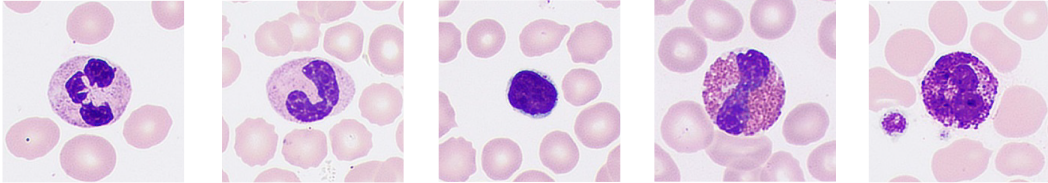
4

Capture a verdade sobre morfologia celular
2021-12-23

Muitos laboratĆ³rios s?o incomodados por problemas como a demora nos processos de anĆ”lise e exames microscĆ³picos menos eficientes devido Ć falta de especialistas em morfologia celular e equipamentos inadequados. Isto faz com que eles tenham dificuldades em alcan?ar uma taxa geral de reexames de 30%, uma meta recomendada pela revis?o do grupo de consenso internacional para hematologia. AlĆ©m disso, as habilidades das equipes de laboratĆ³rio s?o variadas, levando a uma inconsistĆŖncia nos padr?es e resultados do laboratĆ³rio.
O analisador automĆ”tico de morfologia celular MC-80 da Mindray foi projetado para fornecer āMais clareza, mais inteligĆŖncia e mais produtividadeā Ć anĆ”lise da morfologia celular, com ferramentas inteligentes para ajudar a descobrir a verdade sobre as cĆ©lulas.
Empenhada em melhorar a eficiĆŖncia e a precis?o dos laboratĆ³rios, a Mindray tem colaborado com especialistas e estudiosos em hospitais em todo o mundo desde 2014. Com base em pesquisas intensivas, a Mindray desenvolveu solu??es inovadoras em imagem celular, tais como a tecnologia de fus?o de mĆŗltiplas camadas, o sistema anti-vibra??o hiperestĆ”vel āSolid Rockā, a tecnologia Fly-mode e muitas outras.
Mais nitidez: mais detalhes alĆ©m das aparĆŖncias
As cƩlulas s?o as unidades bƔsicas da vida e testes de morfologia celular s?o uma das principais ferramentas para a detec??o de doen?as malignas. Os patologistas estudam a estrutura interna e os detalhes das cƩlulas para vƔrias necessidades.
Atualmente, na maioria dos laboratĆ³rios, os especialistas em morfologia observam as imagens celulares de cada amostra de reanĆ”lise manualmente usando um microscĆ³pio, o que torna este um processo prolongado quando o volume de testes Ć© grande.
A fim de aliviar efetivamente a carga de trabalho de anĆ”lise manual com microscĆ³pios, os analisadores de morfologia celular precisam simular os detalhes capturados pela microscopia manual da forma mais clara possĆvel. Como a imagem plana de cĆ©lulas pode conseguir isso?
O MC-80 captura de forma inovadora 20 imagens de cada cƩlula em diferentes profundidades de campo.

A essĆŖncia da tecnologia de fus?o de mĆŗltiplas profundidades Ć© recriar manualmente o foco que normalmente seria obtido pelo mĆ©dico, sobrepondo as partes claras das 20 imagens. Na imagem celular do MC-80, as caracterĆsticas e detalhes internos das cĆ©lulas normais e anormais podem ser claramente apresentados.

Portanto, os mĆ©dicos podem obter uma vis?o das caracterĆsticas patolĆ³gicas das cĆ©lulas para uma triagem precoce mais precisa dos distĆŗrbios do sangue e das doen?as infecciosas, evitando erros de detec??o.
The essence of the multi-depth fusion technology is to recreate manual focusing normally performed by the doctor by superimposing the clear parts of the 20 images. In the cell imaging from the MC-80, the features and internal details of normal and abnormal cells can be clearly presented.
Therefore, doctors can gain insight into the pathological features of cells for more accurate early screening of blood disorders and infectious diseases, avoiding misdetection.
Mais inteligĆŖncia: oferecendo uma vis?o completa das amostras

Entre as informa??es complexas, as informa??es desordenadas s?o invƔlidas e criam uma barreira entre os mƩdicos e a verdade.
Capturar imagens das cĆ©lulas Ć© apenas o come?o. ? ent?o necessĆ”rio classificar corretamente cada cĆ©lula para refletir a vis?o de conjunto da amostra. Na anĆ”lise manual, o processo de classifica??o frequentemente Ć© registrado um de cada vez pelo mĆ©dico. Entretanto, como os vĆ”rios tipos de cĆ©lulas s?o semelhantes, os mĆ©dicos sĆ³ podem classificĆ”-las com base em seus detalhes. Com o tempo, ocorrem erros que afetam a precis?o e eficiĆŖncia.
Com a identifica??o e prƩ-classifica??o confiƔveis de diferentes tipos de cƩlulas, o MC-80 pode refletir com precis?o a vis?o geral da amostra, ajudando assim os mƩdicos a compreender o estado do paciente.
O reconhecimento preciso Ć© baseado na extra??o precisa das caracterĆsticas das imagens digitais das cĆ©lulas. Com a orienta??o de especialistas em morfologia e patologia no estĆ”gio inicial, a equipe da Mindray extrai as informa??es relativas Ć cor, textura e caracterĆsticas geomĆ©tricas das cĆ©lulas em diferentes escalas. Ao melhorar a taxa de reconhecimento de cĆ©lulas usando classifica??o em cascata, os patologistas podem confirmar com precis?o os tipos de cĆ©lulas pela compara??o dentro de categorias e subcategorias.
Melhorar a taxa de reconhecimento de cƩlulas por classifica??o em cascata

O MC-80 pode ajustar, de forma inteligente, o modo de anĆ”lise antes e durante o processo de acordo com as informa??es da linha de anĆ”lise celular para melhorar a eficiĆŖncia do diagnĆ³stico.


Para a falsa diminui??o da contagem de plaquetas devido a aglomera??o, o MC-80, com seu exclusivo FLY-MODE de alta velocidade, pode escanear o corpo, ambos os lados e a cauda do esfrega?o em um minuto, identificando com precis?o o aglomerado de plaquetas e evitando uma confirma??o manual demorada.
Maior produtividade: melhorando a eficiĆŖncia da anĆ”lise morfolĆ³gica
AtƩ agora, sob ilumina??o estƔvel, a captura de uma imagem clara requer um longo tempo de exposi??o e quase nenhum movimento da c?mera. Parece que velocidade e nitidez n?o podem ser alcan?adas ao mesmo tempo.
O mesmo vale para a anĆ”lise da morfologia celular. AlĆ©m da nitidez, a eficiĆŖncia tambĆ©m Ć© importante para encontrar a verdade mais rapidamente. A anĆ”lise manual tradicional demora de 5 a 8 minutos para cada amostra. Em grandes laboratĆ³rios, a enorme carga de trabalho requer pessoal especializado, resultando em altos custos de m?o-de-obra.
O laboratĆ³rio precisa revisar grandes quantidades de amostras.



Completar os testes mais rapidamente Ć© a Ćŗnica forma de popularizar os exames por microscĆ³pico. O aumento da eficiĆŖncia dos testes de morfologia celular Ć© um objetivo principal na busca da verdade.
O MC-80 consistentemente captura imagens de cĆ©lulas em alta velocidade, processando uma amostra por minuto. Por meio de uma amostragem flexĆvel de uma sĆ³ l?mina, ele pode gerar resultados para casos urgentes rapidamente.
Em compara??o com os analisadores celulares tradicionais, o MC-80 tem muitas caracterĆsticas revolucionĆ”rias.

Quantidade total de imagens geradas por hora

O MC-80 Ć© construĆdo com o sistema anti-vibra??o hiperestĆ”vel SOLID ROCK. ApĆ³s repetidas verifica??es, o novo material aeroespacial pode proporcionar a rigidez exigida pelo MC-80 durante movimentos de alta velocidade. A estrutura estĆ”vel e o algoritmo avan?ado de exposi??o de alta frequĆŖncia podem resolver pequenas perturba??es horizontais e verticais, garantindo uma anĆ”lise celular rĆ”pida, precisa e confiĆ”vel.
Em caso de problemas tĆ©cnicos durante o exame, o MC-80 suporta a valida??o remota em mĆŗltiplos terminais, permitindo a disponibiliza??o imediata da consulta.
Revis?o e consulta remotas em mĆŗltiplos locais

MC-80
Analisador de morfologia celular automatizado digital
Mais nitidez, mais inteligĆŖncia, mais produtividade.
O analisador automĆ”tico de morfologia celular MC-80 da Mindray fornece uma anĆ”lise morfolĆ³gica mais precisa e confiĆ”vel em campo com sua tecnologia lĆder no setor. Ao abordar os principais desafios na anĆ”lise morfolĆ³gica, a Mindray fornece uma solu??o abrangente de anĆ”lise de hematologia automĆ”tica que fortalece a confian?a, fornecendo resultados precisos ao mesmo tempo em que atende Ć s exigĆŖncias de eficiĆŖncia dos laboratĆ³rios em todo o mundo.
















